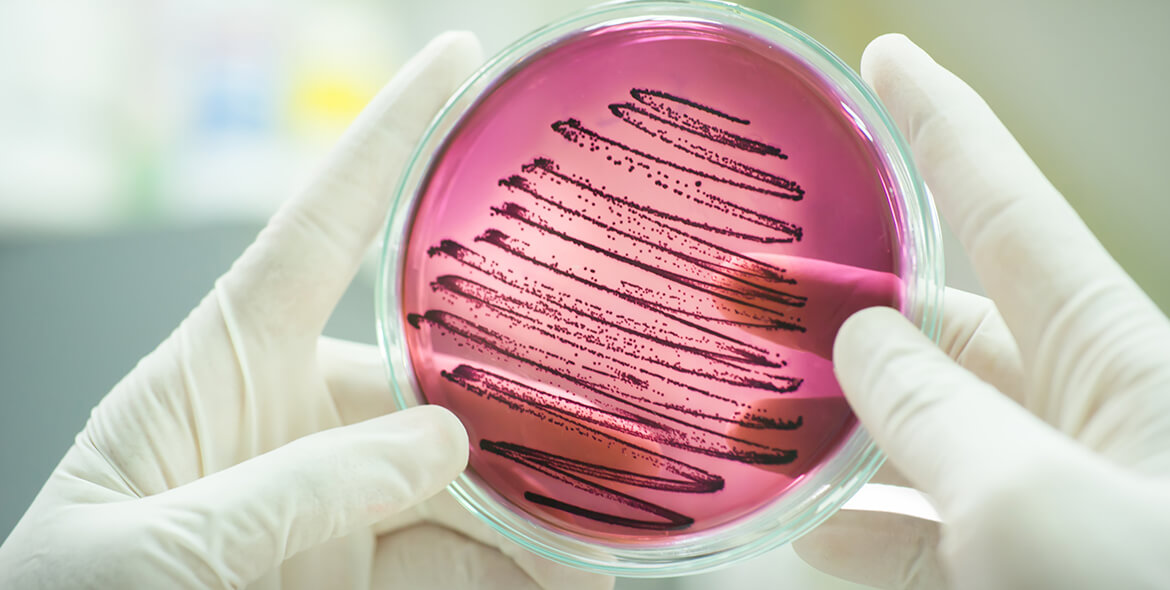

醫學檢驗服務
近年來常有重金屬污染事件,重金屬透過飲食、呼吸、環境或是直接接觸等路徑進入人體,但是重金屬不像其他的毒素可以在肝臟分解代謝,以排出體外,而重金屬是否危害人體健康,環境中的重金屬暴露是否造成身體危害,需要更進一步檢視,才能客觀評估,台美於臨床檢驗服務中提供人體血清重金屬檢驗及各項臨床檢驗服務。
新冠病毒篩檢
為維護工作環境中同仁健康管理、拜訪客戶或出國工作、求學…等需求,定期確認人員健康狀況或提出72小時內陰性檢驗證明,透過RT-PCR核酸檢驗為國際認可快速且正確有效之檢驗方法,台美提供您醫院外的自費檢驗選擇,減少傳染風險,採用獨立採檢空間與預約的採檢時間,兼顧安全與效率。
結核分枝桿菌檢測專家
結核病(Tuberculosis,又稱 TB)為結核桿菌感染引起的疾病,結核通常造成肺部感染,也會感染身體的其他部分,屬於飛沫傳染性疾病,台美受衛生福利部疾病管制署 (CDC) 認可為傳染病檢驗機構,在實驗室生物安全防護等級上,為 P2 plus 等級生物安全實驗室,為國內結核分枝桿菌 (TB) 的檢驗專家。
常見臨床檢驗項目
-
- 人體血清重金屬檢驗(砷、鉛、銅、鋅、硒)
- 各式檢體細菌革蘭氏染色顯微鏡檢查
- 各式檢體細菌培養及鑑定(滲出物、排出物、分泌物、血液、腦脊髓液等)
- 厭氧性菌培養及鑑定
- 細菌藥物敏感性試驗
- 校園除 4 菌篩檢、人體糞便檢驗
結核分枝桿菌 (TB) 檢驗項目
-
- 濃縮抹片抗酸性染色 (Acid-fast stain) 檢查
- 分枝桿菌培養 (Mycobacterium Culture)
- 分枝桿菌鑑定(TB 及 NTM 鑑定)
- 分枝桿菌藥物敏感性試驗(TB 及 NTM 藥敏試驗)
- TB 去氧核糖核酸類定性擴增試驗 (TB-PCR)

你必須登入才能發表留言。